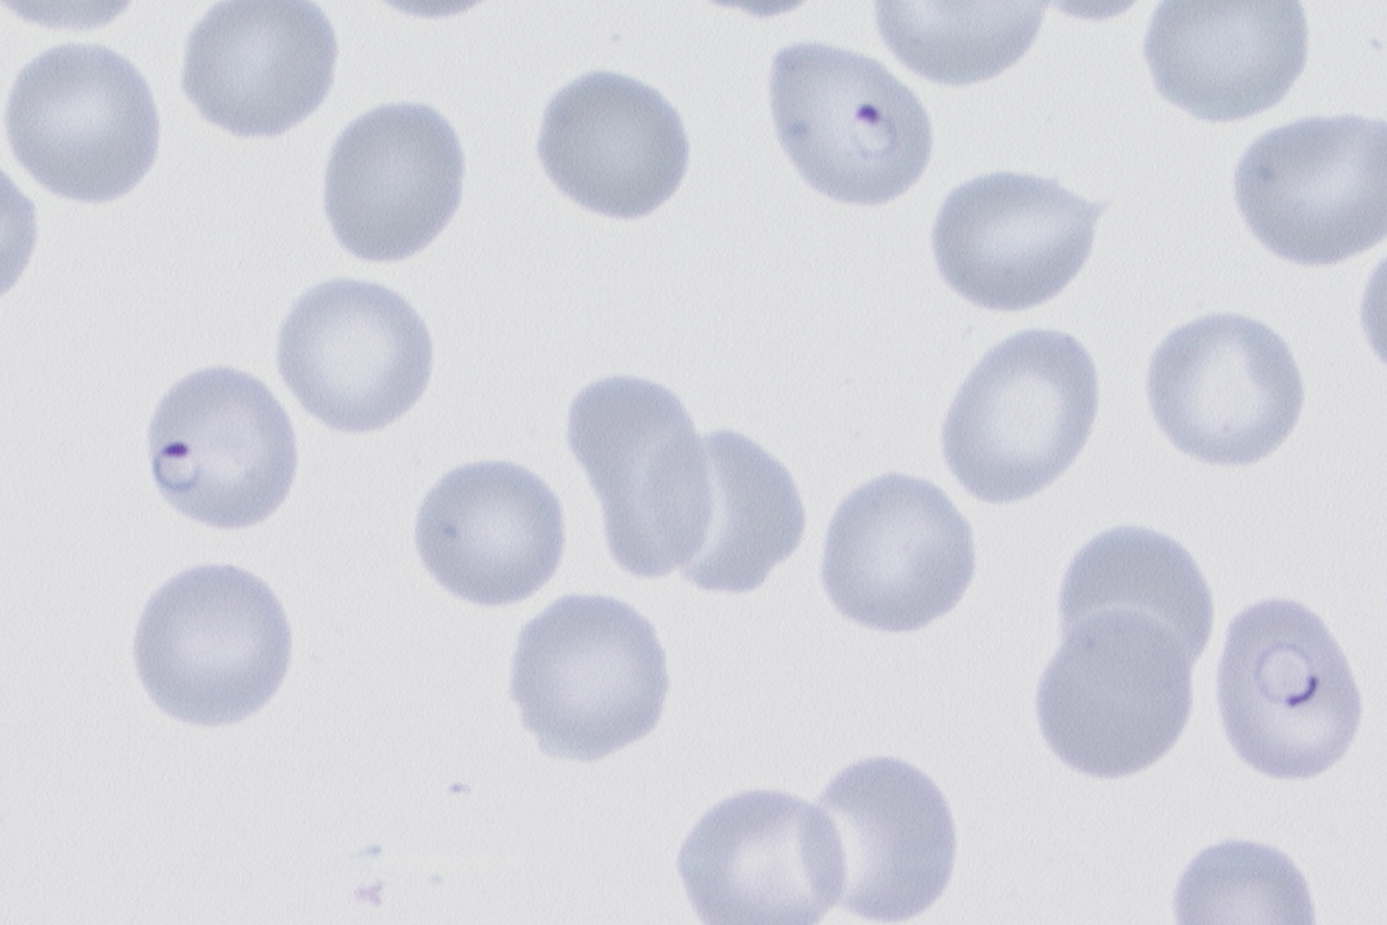
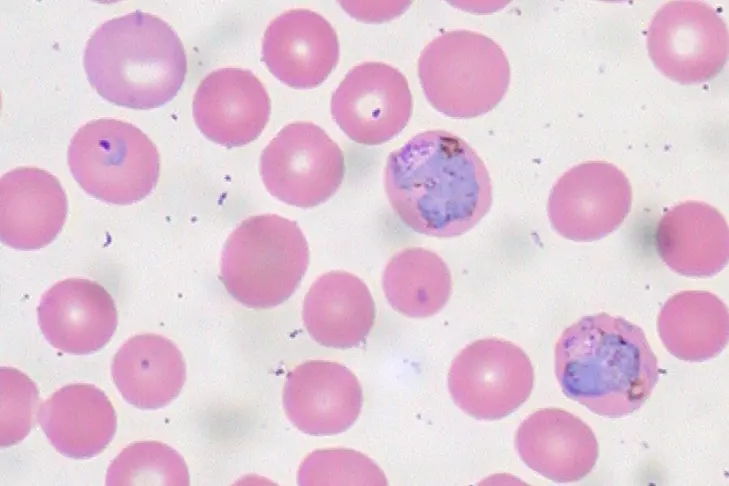

Malaria
Årsak
Malaria forårsakes av encellede parasitter, protozoer, som smitter via mygg. Fem malaria arter gir sykdom hos mennesker: Plasmodium falciparum, P. vivax, P. ovale, P. malariae og P. knowlesi. . P. falciparum og P. knowlesi kan gi alvorlig malaria, mens P. vivax, P. ovale og P. malariae vanligvis gir benign malaria.
Livssyklus og patogenese
Parasittene overføres til mennesker fra mygg av slekten Anopheles og formerer seg i røde blodceller (erytrocytter). Myggen injiserer sporozoitter som kommer seg raskt til leveren, der de modnes til lever-schizonter fylt av umodne datterparasitter, merozoitter. Etter ca en uke sprekker lever-schizonten, og merozoittene invaderer røde blodlegemer der den ukjønnede videre formeringen foregår. Merozoittene modnes til trofozoitter som videre modnes til en erytrocytt-schizont før erytrocytten sprekker og syklusen gjentas. P. falciparum produserer antigener ca halvveis i livssyklusen, som binder seg (cytaodherer) spesifikt til endotel i små kapillærer i organer. Denne ansamlingen, sekvestreringen, av infiserte P. falciparum erytrocytter i organer som hjerne, nyre, lever og placenta fører til metabolsk acidose og inflammasjon og er bakgrunnen for at P. falciparum raskt kan gi livstruende organsvikt. Malariaparasittene formerer seg til nye parasitter i løpet av ett (P. knowlesi), to (P. falciparum, P. vivax og P. ovale) eller tre (P. malariae) døgn, og gir på den måten en rask eksponensiell økning av parasittemi i blodet. Noen parasitter utvikler seg til gametocytter, som ikke gir sykdom hos mennesket, men taes opp av myggen der den kjønnede formeringen skjer. P. vivax og P. ovale har evnen til å bli værende som hypnozoitter i leveren, og kan gi tilbakefall av malaria i uker eller måneder etter første malariaanfall.
Utbredelse
Malaria finnes i den tropiske del av verden der Anopheles myggen lever, og sosioøkonomiske og klimatiske forhold bestemmer hvor stor sykdomsbyrden er. Forekomst av falciparummalaria er svært høy i Afrika sør for Sahara, på det indiske subkontinent, Papua New Guinea og i Amazonasdeltaet i Brasil, og P. vivax er vanlig i deler av Øst-Afrika, Asia og Sør-Amerika. P. knowlesi (Sør-Øst-Asia) er hittil ikke påvist i Norge. Verdens helseorganisasjon (WHO) har anslått at malaria rammet mellom 225 og 278 millioner mennesker og forårsaket mellom 566 000 og 768 000 dødsfall i 2022, men tallene er usikre på grunn av uspesifikk diagnose av febersykdommer og generelt stor grad av underrapportering. I Norge rapporteres det ca 50-100 tilfeller av malaria årlig, der pasienter oftest har blitt smittet med P. falciparum i Afrika sør for Sahara.
Symptomer og tegn
Feber, frostanfall, hodepine, smerter i kroppen, løs avføring og kvalme er vanlige tidlige symptomer. Ved alvorlig malaria får pasienten tegn på organsvikt, og kan få symptomer i form av redusert bevissthet, kramper, alvorlig blodmangel (anemi), nyresvikt, vann på lungene (ARDS og lungeødem), lavt blodsukker (hypoglykemi), sjokk, blødninger, gulsott (Ikterus) og cola-farget urin. Barn og gravide har spesielt høy risiko for rask utvikling til alvorlig forløp.
Kronisk malaria
Immigranter som har vært immune mot malaria i hjemlandet, kan ha kronisk lavgradig malaria uten feber i flere år etter ankomst i Norge. Denne spesielle formen for malaria kan gi anemi, forstørret milt eller komplikasjoner for mor og barn i svangerskap. Kronisk malaria behandles med samme medikamenter og dosering som akutt malaria.
Utredning
Ved feber etter å ha vært i tropene må man raskt søke lege og bli undersøkt for malaria. Det må avklares som øyeblikkelig hjelp om pasienten har P. falciparum malaria. Diagnosen stilles ved hjelp av antigentester og mikroskopi av Giemsa farget tynn- og tykkdråpe blodutstryk (CDC - DPDx - Malaria). Antigentestene er enkle å utføre og tolke, mens tolkning av tynn- og tykkdråpe krever mikroskopør som har erfaring med metoden. Malaria hurtigtest og mikroskopi er rutinemetoder som skal kunne utføres ved alle norske sykehus.
PCR er den mest sensitive metoden som kan være nyttig for kvalitetskontroll av rutinediagnostikken, for eksempel ved mistanke om dobbeltinfeksjon når hurtigtesten slår ut på begge båndene. PCR er indisert ved mistanke om kronisk malaria, der hurtigtest og mikroskopi ofte vil være negativ. Malaria PCR inngår også i multiplex PCR «feberpanel» som gjøres ved noen laboratorier. Mikroskopi er nødvendig for å bestemme prosent parasittemi i blodet, for sikkert å bestemme malaria-art, og for å oppdage andre infeksjoner som ikke inngår i multiplex PCR panelet eller antigentesten.
P. falciparum trofozoitter har typisk to kromatinklumper i en tynn ring. Erytrocyttene er normalt store.
Behandling og forebygging
Alvorlig malaria behandles med artesunat intravenøst, og fullføres med en standard kur med perorale midler når pasienten er i bedring og parasittemi er <1%. Ukomplisert falciparummalaria og de andre malariaartene behandles med perorale medikamenter. Se nasjonal faglig retningslinje for antibiotika i sykehus, «Importerte infeksjonssykdommer», for valg av medikament og dosering.
Malaria kan forebygges med myggstikkbeskyttelse og forebyggende malariamedisiner, se Folkehelseinstituttets nettside for detaljerte råd.
Undervisningsvideo malaria
Malaria klinikk, diagnostikk og behandling (youtube.com)
-------------
Forfattet av Kristine Mørch og Bjørn Blomberg, oppdatert September 2024